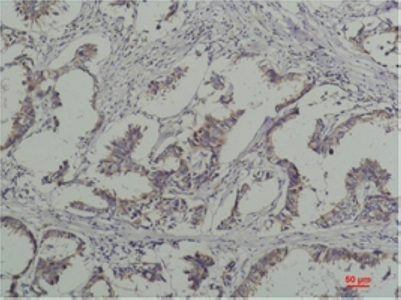

别名:Phospho-Tyrosine应用:WB,IHC
反应种属:Transfected
规格:50μl/100μl
| Description |
|---|
| Tyrosine phosphorylation plays a key role in cellular signaling. Research studies have shown that in cancer, unregulated tyrosine kinase activity can drive malignancy and tumor formation by generating inappropriate proliferation and survival signals. Antibodies specific for phospho-tyrosine have been invaluable reagents in these studies. |
| Specification | |
|---|---|
| Aliases | Phospho-Tyrosine |
| clone | 8B2 |
| WB Predicted band size | Refer to figures |
| Host/Isotype | Mouse IgG1 |
| Storage | Store at 4°C short term. Aliquot and store at -20°C long term. Avoid freeze/thaw cycles. |
| Species Reactivity | Transfected |
| Immunogen | Purified Protein |
| Formulation | Liquid in PBS containing 50% glycerol, 0.5% BSA and 0.02% sodium azide, pH 7.3. |
| Application | |
|---|---|
| WB | 1/500-1/1000 |
| IHC | 1/50-1/100 |
![]() |
Western blot analysis of Phospho-Tyrosine (6G6)in Jurkat, 293T, rat Brain, mouse Brain lysates using Phospho-tyrosine antibody. |
![]() |
Immunohistochemistry analysis of paraffin-embedded Human Breast Caricnoma using Phospho-tyrosine antibody.High-pressure and temperature Sodium Citrate pH 6.0 was used for antigen retrieval. |
本公司的所有产品仅用于科学研究或者工业应用等非医疗目的,不可用于人类或动物的临床诊断或治疗,非药用,非食用。
暂无评论
本公司的所有产品仅用于科学研究或者工业应用等非医疗目的,不可用于人类或动物的临床诊断或治疗,非药用,非食用。
中文

发表回复